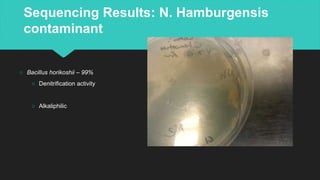
Sequencing Results: N. Hamburgensis
contaminant
○ Bacillus horikoshii – 99%
○ Denitrification activity
○ Alkaliphilic
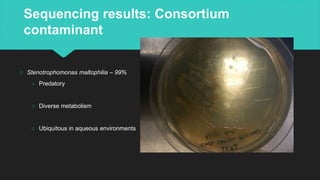
Sequencing results: Consortium
contaminant
○ Stenotrophomonas maltophilia – 99%
○ Predatory
○ Diverse metabolism
○ Ubiquitous in aqueous environments

Seven heterotrophic contaminants were isolated from three nitrifying bioreactors. The contaminants were identified via PCR amplification and sequencing of the 16S ribosomal subunit. From a Nitrobacter hamburgensis bioreactor that crashed, two contaminants were isolated and identified as Gordonia terrae and Microbacterium oxydans. From a stable N. hamburgensis bioreactor, one contaminant was isolated and identified as Bacillus horikoshii. From a Nitrosomonas europaea and Nitrobacter winogradskyi consortium bioreactor, four contaminants were isolated - Shinella zoogloeoides, Flavobacterium lindanitol